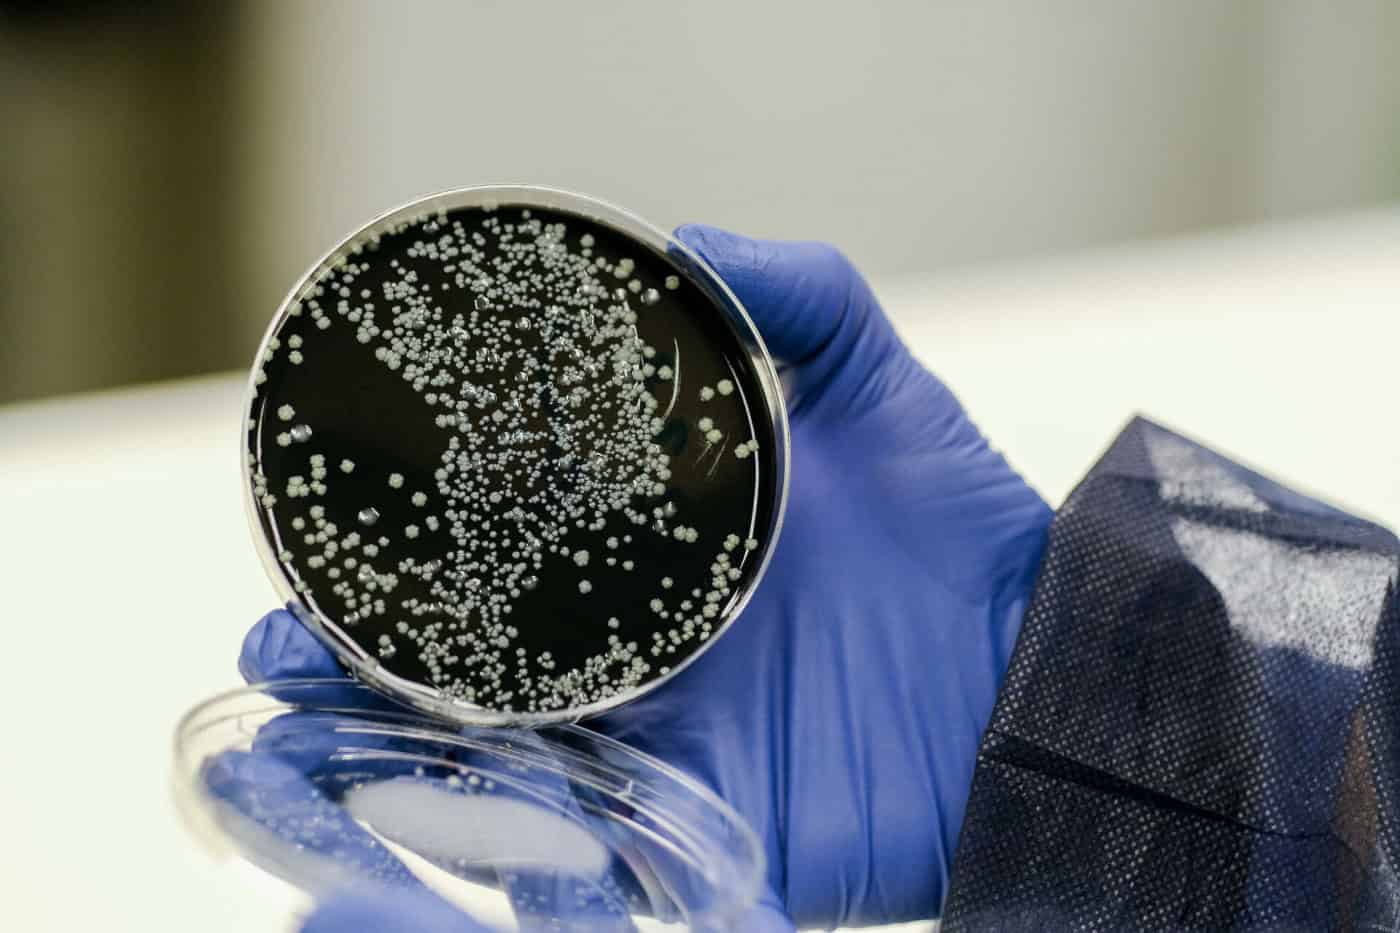
USP Braga apela à colaboração das empresas locais na prevenção de Legionella

USP Braga apela à colaboração das empresas locais na prevenção de Legionella
A Unidade de Saúde Pública de Braga (USP Braga), em colaboração com a InvestBraga e a Proteção Civil de Braga, promove uma iniciativa de prevenção contra a Legionella, apelando à participação ativa de todas as empresas locais.
“O objetivo passa por prevenir o aumento de casos desta doença no concelho, que se tem vindo a manifestar desde o ano de 2022, com uma tendência mais pronunciada a partir de novembro de 2023”, lê-se no comunicado enviado às redações.
Recorde-se que a Legionella, uma bactéria que se desenvolve em ambientes aquáticos, excluindo os marinhos, apresenta uma ameaça à saúde pública. A transmissão ocorre predominantemente pela via aérea, através da inalação de microgotículas de água (aerossóis), podendo desencadear a Doença dos Legionários, uma forma grave de pneumonia atípica.
“Apelamos às empresas a verificar se possuem equipamentos de risco, como os mencionados anteriormente, e garantir o cumprimento das normas legalmente exigidas”, refere o administrador da InvestBraga, Carlos Silva.
Com o intuito de facilitar este processo, será disponibilizado às empresas um documento informativo, que detalha as medidas preventivas essenciais. Além disso, será também solicitado o preenchimento de um formulário ‘Legionella – Plano de Prevenção e Controlo’ para a avaliação de risco específica de cada empresa.
